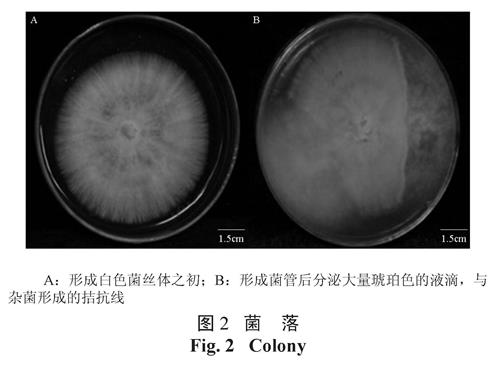

A new pathogenic fungi of Cinnamomum camphora: morphological identification and ITS phylogenetic analysis of Abortiporus biennis
School of Life Science and Engineering, Southwest University of Science and Technology, Mianyang 621010, Sichuan, China
Abortiporus biennis;morphological characteristics;ITS rDNA;phylogeny
基金项目:西南科技大学研究生创新基金项目( 11ycjj41)
作者简介:郑俊娟( 1987-),女 ,江苏丹阳人 ,硕士研究生 ,研究方向 :野生蕈菌资源; E-mail:junjuan_zheng@126.com通讯作者:贺新生( 1965-),男 ,四川金堂人 ,教授 ,主要从事食用药用蕈菌资源研究; E-mail:hexinsheng@swust.edu.cn
-
报道了香樟树的一种新病原菌,对采集的标本及其培养物的形态特征进行观察,对其 ITS区序列进行测定和系统发育分析,将所测得的序列提交至 Genbank获得序列号为 JN182923。通过 Blast比对获得同属近缘的序列后构建系统发育树并进行同源性分析。形态学鉴定和分子鉴定相结合将标本鉴定为二年残孔菌 Abortiporus biennis,由系统发育树推断,二年残孔菌是多元进化的。
A new pathogenic fungi of Cinnamomum camphora was reported. The morphological characteristics and microscopic observation of the pathogen were conducted. The specimen’s ITS rDNA sequence was submitted to Genbank and acquired a gene number JN182923. Through blast comparison we got the relative sequences and made homology analysis by constructed the phylogenetic tree. Combining traditional morphological identification and molecular identification,the ITS rDNA sequence were determined, and ITS rDNA system development was analyzed. The parasite was identified as Abortiporus biennis and the phylogenetic tree indicates that Abortiporus biennis is probably polyphyletic.
引言
在2009 ~ 2010 年秋冬季于绵阳市江油方水镇、绵阳市涪城区香樟树树干基部多次采集到一种残孔菌标本(见图1)。本研究从采集的子实体中分离获得纯菌丝体,进行平板培养获得菌落形态,在实验室成功培养出子实体,对其形态特征进行观察,确定其分类地位;测定分析其ITS 序列,与基因库(GenBank) 中同属近缘序列进行比对,构建系统进化树。
1 材料与方法
1.1 形态特征观察
2009 年11 月10 日在绵阳市江油方水镇,在香樟树根部采集到真菌子实体,保存在西南科技大学菌物标本室(SWUST2009111001)。先对其外部形态特征进行描述,再取少量菌肉组织制成水浸片,在侧置显微镜下进行显微结构观察。从野生子实体中分离获得纯菌丝,进行平板培养获得菌落形态。
1.2 系统发育树的构建
1.2.1 供试菌株
本研究供试菌株包括 25份材料 (见表1),其中二年残孔菌 Abortiporus biennis菌株分离自四川省绵阳市江油方水镇生长在香樟树根部的真菌子实体标本,分离菌株编号 Ab.1,保存在西南科技大学菌种保藏管理中心。本实验测定了它的 ITS序列,其余序列均来自基因库 (GenBank)。

表1 供试菌株
Table 1 Strains used in the study1.2.2 DNA的提取
称取少量采样分离培养的 Ab.1菌株的菌丝,加液氮充分研磨后,迅速转移至 1.5 mL离心管中,用 Universal DNA Genomic Extraction Kit Ver3.0 (大连 TaKaRa, Cat#DV811A)按照其使用说明提取基因组 DNA。
1.2.3 ITS区域的特异性 PCR扩增
选择 ITS-1和 ITS-4这两个引物扩增 ITS的全长序列 ,它们由上海生工生物公司合成。引物序列、 PCR反应体系以及 PCR反应条件和 ITS序列的测定均参考文献 [1]。
1.2.4 ITS序列的分析
将测得的 Ab.1菌株的 rDNA-ITS序列提交到美国 NCBI的 GenBank数据库,获得基因号,并进行 Blast比对,获得指标靠前的 24条相似序列,将这 24个菌株的 rDNA序列通过 Blast工具和 DNAMAN软件( 6.0.40版本)进行比对分析,构建系统进化树。在 Multiple Sequence Alignment 的 Method中选择“ Full Alignment”和 “Try both strands”;在 Output的 Tree /Homology Tree中选择 “Observed Divergency”和 “Toss gaps”,输出树形图。树形图上的百分数表示比较菌株之间的相似度。
2 结果与分析
2.1 形态鉴定
该菌株子实体一年生,盖状,无柄或有短柄,柄侧生或偏生,菌盖单生或覆瓦状叠生,新鲜时间软木栓质,味淡,干后木栓质,质量明显减轻;菌盖半圆形、圆形或扇形,单个菌盖 3~ 12 cm长,宽 2~ 15 cm,厚 5~ 11 mm;菌盖表面新鲜时粉红色、火烈鸟色,有不明显的环纹,被有细而短的绒毛,干后灰白、灰褐色;边缘新鲜时与菌盖表面同色或颜色稍浅,干后同色,内卷。菌肉木栓质,木材色,厚 2~ 8 mm。菌柄不规则,长 0.1~ 10 cm,如果有枯叶或腐烂的木屑覆盖,可以形成分枝状的菌柄,粉红色,木栓质。子实层体近菌管状,孔口表面新鲜时浅褐色至粉红色,手触后变黑色,干后木材色或浅黑褐色;不育边缘不明显;孔口多角形至迷宫状,有时几乎为菌褶状,每毫米 1~ 4个;管口边缘薄,撕裂状;菌管浅木材色,单层,木栓质,长度 3~ 6 mm。孢子印粉白色。孢子宽椭圆形、卵圆形,无色,光滑,大小为 4.5~ 6.0×3.0~ 4.5 mm。上述形态特征与国内外已发表的该菌的研究进行对比 [2-5],将其鉴定为二年残孔菌 Abortiporus biennis。

图1 二年残孔菌的子实体和菌丝体形态
Fig.1 Fruiting body and mycelium morphology of Abortiporus bienni该菌菌丝体白色,气生菌丝旺盛,具有明显的爬壁性,无色素分泌;生殖菌丝管状,透明,有明显的锁状联合。可以在琼脂或其他固体培养基上直接形成子实层。在水平向上的培养基表面只发育子实层,不形成菌盖。在空间位置适当时才形成菌盖,如垂直于地面的培养基表面,或向下有空间的基物表面。与培养皿内污染的杂菌形成明显的拮抗线,表明有一定的抗杂菌能力。在子实体发生过程中,在形成菌管后分泌出大量琥珀色的液滴。
图2 菌落
Fig.2 Colony2.2 亲缘关系比较
将标本 Ab.1测定的 DNA序列提交到 NCBI的 Genbank数据库获得基因号为 JN182923。该序列 671 bp,其中 18S rDNA部分序列 14 bp,ITS1 rDNA序列 267 bp,5.8S rDNA序列 143 bp,ITS2 rDNA序列 221 bp,28S rDNA部分序列 27 bp。供比较的 ITS rDNA序列长度不一致,最长为 Podoscypha multizonata (EU118663) 986 bp,最短为 Hypochnicium lundellii(AY781277)菌株 557 bp。
利用 DANMAN软件分析 25个菌株的 ITS rDNA序列,得到系统进化树(图3)。与 Ab.1(JN182923)亲缘关系较近近的菌株是 A. biennis(FJ608589)、A. biennis(EU232187)和 Podoscypha multizonata(EU118663),与 Genbank中 FJ608589和 EU232187序列相似度达到 100%,确定 Ab.1菌株是残孔菌属的二年残孔菌(A. biennis),由系统发育树推断二年残孔菌( A. biennis)是多元进化的。
3 讨论
二年残孔菌 Abortiporus biennis (Bull.)Singer属于菌物界 Fungi,担子菌门 Basidiomycota,伞菌亚门 Agaricomycotina,伞菌纲 Agaricomycetes,多孔菌目 Polyporales,干朽菌科 Meruliaceae,残孔菌属 Abortiporus(Murrill et al.1904)。二年残孔菌 Abortiporus biennis的同物异名有: Abortiporus distortus (Schwein.) Murrill et al.、Daedalea albida Purton.、Grifola biennis (Bull.) Zmitr. & Malysheva.、Polyporus sericellus Sacc.、Polystictus rufescens (Pers.) P. Karst.、Trametes rufescens (Pers.) G.H. Otth.。主要分布在中国、日本以及西欧等国家,稀生于针叶树上,寄生于许多种类的阔叶树上或地下埋有腐木的地上,导致木材白色腐朽。生长在抗真菌能力很强的香樟树上还是首次发现,造成树叶提前发黄、落叶,生长缓慢,逐渐枯萎、死亡。世界分布广泛:中国、日本、挪威、丹麦、瑞典、英国、澳大利亚、美国;在中国,江苏、浙江、福建、山西、广西、海南等地均有该菌的报道 [2-3],该菌对园林植物造成的危害也越来越严重,逐渐受到关注。对该菌的研究大都是对其进行形态学描述和生态分布调查 [2-5];也有研究发现二年残孔菌 A. biennis具有药用价值,能够抑制肿瘤 [6];二年残孔菌 A. biennis通过分泌草酸而对有毒的金属氧化物有一定的耐受力 [7-9]。

图3 基于 ITS rDNA序列的 Abortiporus系统进化树
Fig.3 Phylogenetic tree of Abortiporus based on ITS rDNA sequences系统进化树中所选取的对比菌株属于不同的属,亲缘关系较近的聚类在一起,但 ITS rDNA序列都在80% 的同源水平上与二年残孔菌A. biennis相似。本研究是首次将二年残孔菌A. biennis 进行详细的形态描述、实验室培养及其ITS 区序列的PCR 扩增测序,根据其ITS 序列构建系统进化树。对二年残孔菌A. biennis 在国内的分布、子实体和菌落形态特征方面提供了重要的新信息,其分子结果有助于更大规模干朽菌科的系统发育研究,为该菌的鉴定提供可靠的依据,同时对该种病原菌的生物防治也有一定的意义。根据形态特征和分子系统分析相结合将Ab.1 菌株鉴定为二年残孔菌A. biennis 是比较科学的。
-
参考文献
- [1] 郑俊娟, 林琦, 刘 伟, 等. 瑞克纤孔菌在皂荚上的首次发现[J]. 菌物学报,2011,30(1): 128-132.
- [2] 周文能, 张东柱. 野菇图鉴[M]. 台北: 远流出版事业股份有限公司,2005:217.
- [3] 戴玉成. 中国储木及建筑木材腐朽菌图志[M]. 北京: 科学出版社,2009:1-2.
- [4] 戴玉成, 崔宝凯. 海南大型木生真菌的多样性[M]. 北京: 科学出版社,2010:1.
- [5] 赵继鼎. 中国真菌志( 第3 卷) 多孔菌科[M]. 北京: 科学出版社,1998:62-63.
- [6] 戴玉成, 杨祝良. 中国药用真菌名录及部分名称的修订[J].菌物学报, 2008,27(8):801-824.
- [7] Graz M, Jarosz Wilkolazka A, Pawlikowska Pawlega B.Abortiporus biennis tolerance to insoluble metal oxides: oxalatesecretion, oxalate oxidase activity, and mycelia morphology [J].BioMetals, 2009, 22(3):401-410.
- [8] 周再知, 陈 羽, 梁坤南, 等. 乡土用材树种与红菇菌高效共生体的筛选研究[J]. 中南林业科技大学学报 ,2011, 31(2):7-14.
- [1] 郑俊娟, 林琦, 刘 伟, 等. 瑞克纤孔菌在皂荚上的首次发现[J]. 菌物学报,2011,30(1): 128-132.
中南林业科技大学学报